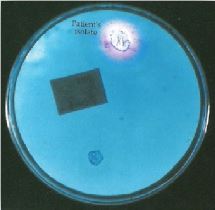

النبات

مواضيع عامة في علم النبات

الجذور - السيقان - الأوراق

النباتات الوعائية واللاوعائية

البذور (مغطاة البذور - عاريات البذور)

الطحالب

النباتات الطبية


الحيوان

مواضيع عامة في علم الحيوان

علم التشريح

التنوع الإحيائي

البايلوجيا الخلوية


الأحياء المجهرية

البكتيريا

الفطريات

الطفيليات

الفايروسات


علم الأمراض

الاورام

الامراض الوراثية

الامراض المناعية

الامراض المدارية

اضطرابات الدورة الدموية

مواضيع عامة في علم الامراض

الحشرات


التقانة الإحيائية

مواضيع عامة في التقانة الإحيائية


التقنية الحيوية المكروبية

التقنية الحيوية والميكروبات

الفعاليات الحيوية

وراثة الاحياء المجهرية

تصنيف الاحياء المجهرية

الاحياء المجهرية في الطبيعة

أيض الاجهاد

التقنية الحيوية والبيئة

التقنية الحيوية والطب

التقنية الحيوية والزراعة

التقنية الحيوية والصناعة

التقنية الحيوية والطاقة

البحار والطحالب الصغيرة

عزل البروتين

هندسة الجينات


التقنية الحياتية النانوية

مفاهيم التقنية الحيوية النانوية

التراكيب النانوية والمجاهر المستخدمة في رؤيتها

تصنيع وتخليق المواد النانوية

تطبيقات التقنية النانوية والحيوية النانوية

الرقائق والمتحسسات الحيوية

المصفوفات المجهرية وحاسوب الدنا

اللقاحات

البيئة والتلوث


علم الأجنة

اعضاء التكاثر وتشكل الاعراس

الاخصاب

التشطر

العصيبة وتشكل الجسيدات

تشكل اللواحق الجنينية

تكون المعيدة وظهور الطبقات الجنينية

مقدمة لعلم الاجنة


الأحياء الجزيئي

مواضيع عامة في الاحياء الجزيئي


علم وظائف الأعضاء


الغدد

مواضيع عامة في الغدد

الغدد الصم و هرموناتها

الجسم تحت السريري

الغدة النخامية

الغدة الكظرية

الغدة التناسلية

الغدة الدرقية والجار الدرقية

الغدة البنكرياسية

الغدة الصنوبرية

مواضيع عامة في علم وظائف الاعضاء

الخلية الحيوانية

الجهاز العصبي

أعضاء الحس

الجهاز العضلي

السوائل الجسمية

الجهاز الدوري والليمف

الجهاز التنفسي

الجهاز الهضمي

الجهاز البولي


المضادات الميكروبية

مواضيع عامة في المضادات الميكروبية

مضادات البكتيريا

مضادات الفطريات

مضادات الطفيليات

مضادات الفايروسات

علم الخلية

الوراثة

الأحياء العامة

المناعة

التحليلات المرضية

الكيمياء الحيوية

مواضيع متنوعة أخرى

الانزيمات
الحالات المرضية البكتيرية : الحالة السادسة
المؤلف:
عبد الرزاق سليمان التومي ، محمد محمد الامام ، عبد الباسط رمضان
المصدر:
اساسيات التشخيص البكتريولوجي المعملي والسريري
الجزء والصفحة:
29-8-2016
2189
الحالات المرضية البكتيرية : الحالة السادسة
رجل مسن تم تشخيص حالته المرضية على أنها أنفلونزا بعد الكشف عليه من قبل الطبيب العام ، وتم التأكد من هذا التشخيص بإجراء الاختبارات المصلية ، وبمرور الأيام زادت حالته الصحية سوءاً فتم إيوانه المستشفى حيث كانت حرارته مرتفعة مع ملاحظة إفرازه كميات كبيرة من البصاق الصديدي purulent sputum . الأشعة السينية التي أجريت له أوضحت وجود multiple abscesses . تم إرسال عينة من البصاق للمختبر لتحليلها مجهرياً كما في الشكل رقم 1 ، وزراعتها على الأوساط الغذائية المناسبة. نتيجة التحليل أوضحت أن الكائن الدقيق الذي تم عزله بأنه موجباً لاختبار التجلط coagulase + ve ، والشكل رقم 2 يوضح نتيجة اختبار إنتاج إنزيم الحمض النووي DNase .

الشكل رقم 1 : نتيجة عينة البصاق
الشكل رقم 2 : نتيجة اختبار انتاج إنزيم الحمض النووي DNase
الأسئلة :
1- ما تعريفك الكائن الدقيق الذي تم عزله ؟
2- ما هي الاستقصاءات الأخرى التي يرتى من الضروري إجرائها؟
3- ما هو المضاد الحيوي الفعال لعلاج هذه الحالة ؟
الإجابة :
1- غالباً ما يكون النوع البكتيري Staphylococcus aureus المسبب الرئيسي للإلتهاب الرئوي الحاد الذي يلي الإصابة بمرض الأنفلونزا ، وهذا النوع من البكتيريا غالباً ما يتسبب في وجود خراج في الرئة . الإصابات الرئوية بهذا النوع من البكتيريا غالباً ما يصيب الأشخاص الذين يعانون من مرض cystic fibrosis ، وعند صبغ عينة البصاق نلاحظ وجود خلايا بكتيرية موجبة لصبغة جرام ، وتظهر هذه الخلايا على هيئة كريات متجمعة. كما أن النتيجة الموجبة لكل من اختبار التجلط واختبار الكشف على انتاج إنزيم الحمض النووي تدل على أن الكائن الدقيق المعزول هو النوع البكتيري S. aureus ومن المعروف أن هناك عدة انواع أخرى من هذه البكتيريا والتي تكون سالبة لاختبار التجلط وهي تشكل الفلورا الطبيعية للجلد وغالباً ما تكون مسببة لبعض الأمراض الناجمة عن دخول أي جسم غريب عبر الجلد ، ومن هذه الأمراض على سبيل المثال التهاب بطانة القلب نتيجة استبدال الصمام prosthetic valve endocarditis والتهاب المفاصل الصناعية infected joint prostheses والتهاب القسطرة الوريدية infected venous catheter.
2- في مثل هذه الحالة ، غالباً ما يكون المريض مصاب بتجرثم الدم ، فإذا لم يستجيب المريض للعلاج او حدثت له انتكاسة فعندها يتوقع إصابته بالتهاب العظام أو التهاب بطانة القلب أو وجود خراج حول الكلية ، ومن هنا فإنه من الضروري إجراء بعض التحاليل الجرثومية والاشعاعية كزراعة عينة من الدم والكشف عن القلب باستعمال تخطيط صدى القلب echocardiography وكذلك إجراء كشف على منطقة البطن باستعمال تقنية الموجات فوق الصوتين abdominal ultrasound .
3- مع ان أغلب سلالات هذه البكتيريا حساسة للمضاد الحيوي flucloxacillin والذي ينصح باستعماله لعلاج هذه الحالة مضافاً إليه المضاد الحيوي fusidic acid أو المضاد الحيوي gentamicin. إلا أنه لاختيار المضاد الحيوي الفعال لعلاج هذه الحالة المرضية فلا بد من إجراء اختبارات حساسية الكائن الدقيق المعزول لعدة انواع من المضادات الحيوية.
 الاكثر قراءة في البكتيريا
الاكثر قراءة في البكتيريا
 اخر الاخبار
اخر الاخبار
اخبار العتبة العباسية المقدسة

الآخبار الصحية















 قسم الشؤون الفكرية يصدر كتاباً يوثق تاريخ السدانة في العتبة العباسية المقدسة
قسم الشؤون الفكرية يصدر كتاباً يوثق تاريخ السدانة في العتبة العباسية المقدسة "المهمة".. إصدار قصصي يوثّق القصص الفائزة في مسابقة فتوى الدفاع المقدسة للقصة القصيرة
"المهمة".. إصدار قصصي يوثّق القصص الفائزة في مسابقة فتوى الدفاع المقدسة للقصة القصيرة (نوافذ).. إصدار أدبي يوثق القصص الفائزة في مسابقة الإمام العسكري (عليه السلام)
(نوافذ).. إصدار أدبي يوثق القصص الفائزة في مسابقة الإمام العسكري (عليه السلام)


















